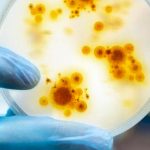
Ministerio de Salud confirma primer caso de viruela del mono en Uruguay Uruguay recordó a población consultar prestador de salud

Etiqueta: viruela del mono
Ministerio de Salud confirma primer caso de viruela del mono en Uruguay
Este viernes el Ministerio de Salud Pública (MSP) de Uruguay confirmó el descubrimiento en Montevideo del primer caso de viruela del mono en el...
OMS afirma que la vacuna contra la viruela del mono demora en inmunizar
De acuerdo a la experta de la enfermedad viruela del mono por parte de la Organización Mundial de la Salud (OMS) las vacunas contra...
OMS declara emergencia sanitaria por el brote de viruela de mono
Ante el aumento de los casos de la viruela del mono en todo el mundo, la Organización Mundial de la Salud (OMS) decidió este...
Aumentan 77% los casos de viruela del mono en una semana, dice la OMS
Los casos de viruela del mono confirmados por un laboratorio registraron un aumento semanal de 77%, a más de 6 mil personas en todo...
¡Descubrimiento! Primeros brotes de viruela del mono en niños
La viruela del mono se ha detectado en recientes semanas en al menos 5 niños de corta edad en Europa, en tanto el brote...
Se confirmó primer caso de viruela del mono en Puerto Rico
Este miércoles se confirmó el primer caso de viruela del mono en la isla caribeña; así lo anunció el secretario del Departamento de Salud...
OMS contabiliza más de 3.400 casos de viruela del mono en 50 países
Este lunes mediante un comunicado de la OMS - Organización Mundial de la Salud, se dio a conocer que se han contabilizado casi alrededor...
Confirmado por el Minsa el primer caso de viruela del mono en Perú
Ya está confirmado el primer caso de viruela del mono en Perú, así lo anunció el ministro de Salud, Jorge López Peña. Dicho contagiado...
La OMS investiga si la viruela del mono se transmite mediante el semen
La viruela del mono presenta 1 mil 160 casos en Europa, la Organización Mundial de la Salud (OMS) atiende los pacientes que presentaron contagio...
¿Las erupciones que causa la viruela del mono dejan cicatrices?
La viruela del mono, la enfermedad vírica que se contrae a raíz del contacto animal-humano. Esta puede ser detectada a través de varios síntomas,...